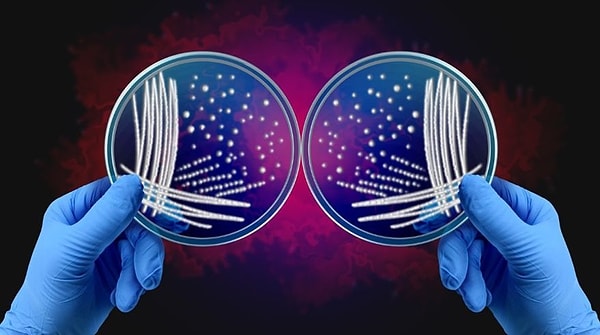

Yaşamı Tehdit Edebilecek "Ayna Hücre" Çalışmaları Durduruldu! Bilim Dünyası Alarmda
Minnesota Üniversitesi’nden biyolog Kate Adamala, laboratuvarındaki araştırmaların sandığından çok daha tehlikeli bir yöne gittiğini fark etti. Ekibiyle birlikte canlıların moleküler yapısını tersine çeviren 'ayna hücre' deneyleri yürütüyordu. Başlangıçta yaşamın kökenini çözmeyi ve yeni tedavilere kapı aralamayı hedefleyen proje, kısa sürede tartışmalı hale geldi.
Bilim insanları, doğanın dengesini bozabilecek bu olasılığın artık göz ardı edilemeyeceğini söylüyor...
İlk önce şu soruyla başlayalım: Ayna hücre nedir ve neden riskli kabul ediliyor?

Canlıların genetik yapısında her şey belli bir düzene göre işler. Bilim insanları buna 'kiralite' yani moleküllerin sağ ya da sol yönelimli olması diyor. En basit haliyle sağ elin sol ele uymaması gibi düşünebilirsiniz. Her canlı bu düzenle hayatta kalıyor.
Ayna hücre fikri ise bu düzeni tersine çevirmeyi hedefliyordu. Kulağa bilim kurgu gibi geliyor ama teoride hastalıkların tedavisinde devrim yaratabilecek bir buluş olabilirdi.
Sorun şu ki, bu hücreler insan bağışıklığı tarafından tanınamayacak kadar farklı. Vücuda girerse tespit edilmeden çoğalabilir, hatta mevcut antibiyotikler hiçbir işe yaramayabilir. Stanford’dan David Relman’a göre, böyle bir yapı doğaya karışırsa sonuçları tahmin edilemeyecek kadar büyük olurdu.
2023 ve 2024’te 38 bilim insanı konuyla ilgili kapsamlı bir rapor hazırladı.
Science dergisinde yayımlanan bu çalışmada, ayna hücrelerin önümüzdeki 10 ila 30 yıl içinde oluşturulabileceği öngörülüyor. Ancak olası sonuçlar oldukça ciddi.
Rapor, böyle bir hücrenin doğaya karışması halinde biyolojik dengeyi tamamen bozabileceğini belirtiyor. Ayna bakteriler, doğal yaşam formlarıyla etkileşime girdiğinde durdurulamaz bir şekilde yayılabilir. Çünkü doğadaki hiçbir virüs ya da bakteri bu yapıları tanıyamaz. Uzmanlara göre insanlık için geri dönülmez bir biyolojik risk anlamına geliyor.
Kate Adamala, bu konudaki tartışmaların ardından projenin yönünü değiştirme kararı aldı. Kendi ifadesine göre, araştırmayı sürdürmek yerine bu konudaki etik sınırları tartışmanın daha doğru olacağına karar verdiler.
2025’in başında yaklaşık yüz bilim insanı, araştırma fonlarını yöneten kurumlar ve politika yapıcılarla bir araya gelerek ortak bir çağrı yaptı.

Bildiride, ayna yaşam formlarının oluşturulmaması gerektiği açıkça belirtildi. Minnesota’daki ekip de bu uyarıların ardından projeyi tamamen sonlandırdı.
Tartışma ise tam anlamıyla kapanmış değil. Bazı bilim insanları, ayna moleküllerin tıp alanında önemli bir potansiyele sahip olduğunu düşünüyor. Utah Üniversitesi’nden biyokimyacı Michael Kay, bu yapıların kontrollü biçimde incelenirse gelecekte yeni tedavi yöntemlerine ilham verebileceğini söylüyor.
Yine de çoğu uzmana göre bilim, bazen neyi yapabileceğinden çok, neyi yapmaması gerektiğini bilmek zorunda.
Keşfet ile ziyaret ettiğin tüm kategorileri tek akışta gör!





Yorum Yazın
Saçma sapan Dilan Polat haberlerinden sonra düzgün bir şey okumak iyi geldi keşke daha çok böyle içerik olsa
Doğada her canlı uyum içinde dengeli yaşayabiliyor insanoğlu hariç. Kendi sonunu getirecek tek canlı yine insanoğlu
Çok gereksiz işlerle uğraşmak var olan bir sistemi değiştirmek yerine var olan üzerindeki problemleri düzeltmeye biraz kafa yorsaniz insanlık namına bir fayd... Devamını Gör